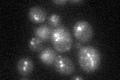
YPL045W
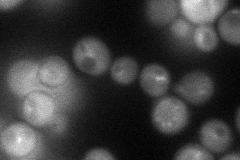
YPL045W
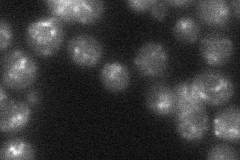
YPL045W
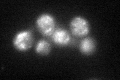
YPL045W

View description
Subunit of the vacuole fusion and protein sorting HOPS complex and the CORVET tethering complex; part of the Class C Vps complex essential for membrane docking and fusion at Golgi-to-endosome and endosome-to-vacuole protein transport stages
Localization:
Intensity:
Fold change:
Significance:
-
C’ GFP library in SD
punctate27.58 -
N' NOP1pr-GFP in SD
cytosol,punctate57.3092 -
N' TEF2pr-mCherry in SD

missing0 -
N' NATIVEpr-GFP in SD
punctate26.8506 -
N' TEF2pr-VC and Cyto-VN in SD

#N/A0 -
C’ GFP library in SD+DTT
punctate30.421.1No -
C’ GFP library in SD+H2O2

punctate26.30.95No -
C’ GFP library in Starvation Media

punctate33.641.21No -
C’ GFP library on the background of Pup2-DaMP

punctate -
C’ GFP library on the background of CCT mutant

punctate28.04931.01674No
